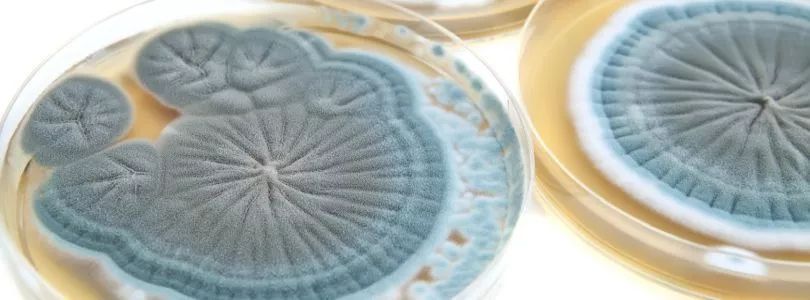
Boom!!杀菌就是爆炸!哈佛科学家终于揭开青霉素炸开细菌的50年谜题丨科学大发现

1928年,青霉素出现在了弗莱明先生的培养皿上,让原本生长着葡萄球菌的培养基出现了一个“空白圈”,开启了人类使用抗生素对抗细菌的大门。
为了破解那个“空白圈”——青霉素的杀菌机制——之谜,科学家在显微镜底下观察了青霉素对细菌的*伤杀**作用。
结果看到了让人惊讶的一幕。
细菌一个接一个,嘭!嘭!嘭!地爆炸了……

左:接连破裂的细菌 右:正常生长的细菌
青霉素究竟是如何引爆了细菌?
随后,经过近30年的探索,有很多科学家认为,这主要是因为作为β-内酰胺类抗生素,青霉素能与细胞壁合成酶青霉素结合蛋白(PBP)结合,抑制细菌细胞壁中肽聚糖的交联[1],最终导致细胞壁越来越脆弱,细菌最终像过度吸水的大豆撑破细胞壁一样,炸裂而亡。
这一传统认知,在1970年被打破。
来自洛克菲勒大学的三位科学家,用他们开创性的研究成果改变了上述观点:青霉素让细菌爆炸,依赖于一种降解细胞壁肽聚糖的酶——自溶素[2]。
(图源:dpma.de)
一石激起千层浪。
随后,科学家发现β-内酰胺类抗生素诱导的其他细菌爆炸,都是依赖于自溶素。
在细菌的生长过程中,自溶素参与了许多关键的细胞过程,对细菌的生长极其重要。令人遗憾的是,自溶素等肽聚糖降解酶是如何被精密调控,以及这个过程是如何被青霉素破坏的这两个问题,至今无人能解。
来自哈佛医学院的David Rudner教授领衔的研究团队,终于破解了这个困扰学界近50年的谜题,发现了青霉素让细菌“爆炸”的秘密。文章发表在著名期刊eLife上[3]。
在耐药菌频现的今天,Rudner教授的这个新发现,对于开发新的抗生素意义非凡。

通讯作者Rudner教授
(图源:harvard.edu)
在揭秘Rudner教授团队的发现之前,有必要给大家介绍下细菌的生长繁殖过程,以及已经发现的青霉素的作用机制。
细菌细胞和人体细胞最主要的差别之一,就是细菌有细胞壁,而人体细胞没有。青霉素等β-内酰胺类抗生素正是基于这个差别,强效*击狙**细胞壁,杀灭细菌,而不伤害人体细胞。
我们都知道,根据细菌的细胞壁组成,细菌可以通过染色分为革兰氏阳性和革兰氏阴性细菌,其中革兰氏阳性菌细胞壁含有肽聚糖。
肽聚糖像个盔甲一样,保护着细菌柔软的原生质体,避免原生质体因过度吸水而被涨破。之前的研究认为,青霉素的作用靶点是肽聚糖合成酶PBP。青霉素抑制PBP活性,导致细胞壁变得脆弱,最终破裂而死。这与科学家在显微镜下观察到的现象也是吻合的。

细胞壁肽聚糖链接示意图,绿色为PBP
不过,洛克菲勒大学的三位科学家却在1970年发现,抑制肺炎链球菌的自溶系统,可以让这些细菌对青霉素产生耐药性。
怎么抑制了一条与青霉素作用机制无关的通路,就让原本对青霉素敏感的细菌耐药了呢?
答案竟然是,青霉素的抗菌机制依赖于肽聚糖的降解机制,而抑制肽聚糖的合成实际上是不足以导致细菌爆炸的。
那么青霉素又是如何调节细菌的肽聚糖的降解的呢?Rudner教授团队解开了这个谜题。

我们都知道,细菌会长大,而且在分裂的时候会直接一分为二,这些生命活动需要细胞壁分裂或者露出一些小缺口[4,5]。
那么,在存在一个坚实细胞壁的情况下,细菌究竟是如何完成上述过程的呢?其实,细菌老早就给自己准备了可以分解细胞壁的酶——肽聚糖水解酶(LytA),也就是前面介绍的自溶素。
以肺炎链球菌为例,在细菌的生长繁殖过程中,肽聚糖水解酶是一直存在的。甚至在细菌快速繁殖的指数生长期,肽聚糖水解酶都保持着较为稳定的水平。
而当细菌生长到了稳定期,少数细菌就会出现类似青霉素处理引起的炸裂现象。科学家将这种现象称为“自溶”。出现自溶的原因,就是肽聚糖水解酶LytA等自溶素失控导致的。

那肽聚糖水解酶这把双刃剑是如何被细菌控制的呢?
奇点糕看完这个过程,只想用一个词评价:巧妙!
原来,在正常情况下,肽聚糖水解酶是被一种叫做细胞膜磷壁酸(LTAs)的物质固定在细胞膜上的,由于细胞膜与细胞壁之间有一定的距离,所以肽聚糖水解酶与细胞壁相安无事。
不过呢,膜磷壁酸的形成,受一个叫做TacL的酶控制[7]。如果TacL没了,膜磷壁酸就不能形成,与此同时,另外一种叫做细胞壁磷壁酸(WTAs)的物质就大量合成了。而这个细胞壁磷壁酸也能固定肽聚糖水解酶,如此这般,肽聚糖水解酶就被固定到细胞壁上,开始对细胞壁上的肽聚糖进行降解。

磷壁酸合成的那些事儿
写到这里,恐怕你已经猜到了,青霉素影响的应该就是这个TacL。
的确如此,当研究人员把青霉素加入肺炎链球菌的培养基,果然发现了TacL水平降低,原本被固定在细胞膜上的肽聚糖水解酶转移到了细胞壁上,肽聚糖被降解,细胞失去细胞壁保护,大量水涌入细胞,细胞膜不堪重负。
终于,炸了。
在研究人员的努力下,终于揭开了肽聚糖水解酶的调控蛋白TacL的神秘面纱,也进一步解释了始祖抗生素青霉素是如何打击犯罪*破爆**肺炎链球菌的。当然,最重要的是,为消灭致病菌提供了新的靶点和治疗思路。
抗生素和细菌的这场battle,还没有结束~
编辑神叨叨
如果想及时获取第一手科研资讯,那你绝对不能错过瞬息~而瞬息又推出了全新版块——瞬间。瞬间可以给大家提供更多:
比如全球新药研发的动态;
比如最新学术研究的热辣点评;
比如一线临床医生的所做所思;
还比如,比如你医学工作中的某一个瞬间。。。
只要有那么一瞬间,有一百万种可能。点击瞬间图片↓↓↓,分享你的医学时光吧!
参考资料:
[1] Park JT, Strominger JL. Mode of action of penicillin[J]. Science,1957,125:99–101.
[2]Tomasz A, Albino A, Zanati E, et al. Multiple Antibiotic Resistance in a Bacterium with Suppressed Autolytic System[J]. Nature, 1970, 227(5254): 138-140.
[3]Flores-Kim J, Dobihal G S, Fenton A, et al. A switch in surface polymer biogenesis triggers growth-phase-dependent and antibiotic-induced bacteriolysis[J]. eLife, 2019, 8: e44912.
[4]De Las Rivas B, García J L, López R, et al. Purification and polar localization of pneumococcal LytB, a putative endo-β-N-acetylglucosaminidase: the chain-dispersing murein hydrolase[J]. Journal of bacteriology, 2002, 184(18): 4988-5000.DOI:10.1128/JB.184.18.4988-5000.2002
[5]Bisicchia P, Noone D, Lioliou E, et al. The essential YycFG two‐component system controls cell wall metabolism in Bacillus subtilis[J]. Molecular microbiology, 2007, 65(1): 180-200. DOI:10.1111/j.1365-2958.2007.05782.x
[7]Heß N, Waldow F, Kohler T P, et al. Lipoteichoic acid deficiency permits normal growth but impairs virulence of Streptococcus pneumoniae[J]. Nature communications, 2017, 8(1): 2093. DOI:10.1038/s41467-017-01720-z


本文作者 | 王雪宁 BioTalker